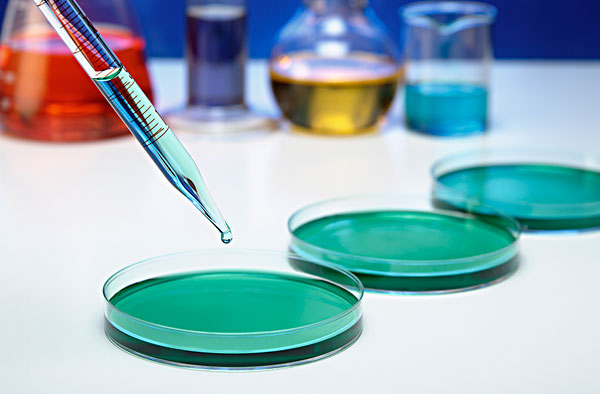

天津市成功研發(fā)甜菊糖甙生產新工藝
發(fā)布時間:2015-04-22
甜菊糖甙是從甜葉菊的葉子中提取出的新型天然甜味劑,具有高甜度低熱值。甜菊糖用于飲料、食品,人長期食用不易發(fā)胖,特別適于肥胖癥、糖尿病等病癥患者食用,安全性高。除我國外,日本、韓國、巴西、馬來西亞、巴拉圭、泰國、新加坡、臺灣等20多個國家和地區(qū)批準甜菊糖甙為食品添加劑使用。甜菊糖甙生產工藝的突破解決了我國高純度的甜菊糖甙不能規(guī)?;a,產品質量不穩(wěn)定的問題。
天津美倫醫(yī)藥集團在天津市科技創(chuàng)新專項“甜菊糖甙深加工新工藝研究及產業(yè)化”項目的支持下,經過數年自主研發(fā)和技術攻關,開發(fā)出一套甜菊糖甙深加工新工藝,提出了一套具有自主知識產權的、可產業(yè)化的提取制備高品質甜菊糖甙(R-A、STV)的生產技術工藝路線,建成年產1000噸總甙生產線一條,1000噸高品質甜菊糖甙生產線一條。
該工藝采用膜過濾和大孔吸附樹脂相結合的技術進行甜菊糖總甙的產業(yè)化生產,提取溶媒水被重復利用,降低了成本,提高了收率,實現(xiàn)清潔生產。項目產業(yè)化后對原料需求將大幅提高,對于發(fā)展甜菊種植特色農業(yè),提高農民收入,促進了區(qū)域經濟發(fā)展具有重要意義。目前該公司產品被國內外眾多客戶認可,市場逐步打開,產品銷往美國、澳大利亞、埃及等國家。